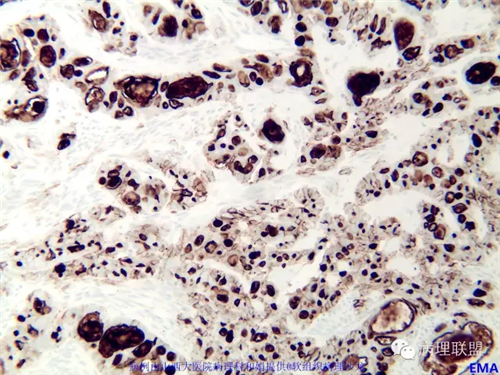

M,57岁,右膝关节外侧皮下肿物10余年,活动度好。
免疫组化结果阴性:S-100,SMA,Calponin,CD10,CD99,CD34,CEA,PHH3。

(注:病例由山西大医院病理科和娟 提供 致谢!)
本例形态学上是非常典型的双相型滑膜肉瘤,滑膜肉瘤临床上大部分表现为生长缓慢的肿瘤。以青壮年多见,主要发生于四肢大关节附近,也可见于其他少见部位,如肺、肾等实质器官,形态学分为5种类型:单相纤维型、单相上皮型、双相型、低分化梭形细胞型和小细胞型。有文献报道个别患者有长达20年的病史。

梅开勇,主任医师,中国医促会病理专委会常委,中华医学会病理学分会骨与软组织疾病学组委员,中国病理工作者委员会淋巴瘤学组委员,广东省抗癌协会肿瘤病理专委会委员,广东省医师协会病理学分会委员,广东省抗癌协会淋巴瘤专委会委员,广东省医疗行业协会病理学分会委员。
从事病理诊断工作20年,熟练掌握常见疾病、细胞学、手术中快速病理诊断,尤其擅长淋巴造血组织、软组织和神经系统肿瘤的疑难病理诊断。2010 – 2011年 Department of Pathology &Immunology, Washington University in St.Louis School of Medicine做访问学者,师从Dengfeng
Cao(曹登峰)教授,学习外科病理诊断,侧重消化系统疾病、泌尿系统疾病、妇科肿瘤病理诊断学习。2012– 2013年 Department of Pathology, Queen Elizabeth Hospital进修外科病理,师从国际著名病理学家John K. C. Chan(陈国璋)教授。主要从事淋巴造血系统肿瘤及神经系统肿瘤研究,主持承担2项广东省卫生厅基金项目,4项广州市卫生局基金项目,参与多项广东省自然、科技厅、中医局药及市卫生局基金项目,发表论文十余篇,SCI文章4篇,参与编写专著三部,主译专著一部。《中国肿瘤临床》及《中华脑科疾病与康复杂志》特约审稿人。作为项目负责人,连续数年成功举办国家级塈广州市级继续医学教育项目《肿瘤病理诊断新进展》学习班。